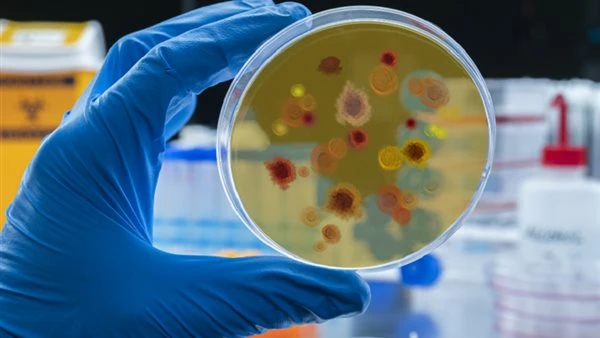
لقاح مبتكر ضد الملاريا يحقق نتائج أولية واعدة في التجارب العلمية

معلومات شاملة عن الذكاء الاصطناعي
• ما هو الذكاء الاصطناعي؟
الذكاء الاصطناعي (AI) هو قدرة الآلات على محاكاة الذكاء البشري، مثل التعلم، الفهم، التحليل، واتخاذ القرارات.
• كيف يعمل الذكاء الاصطناعي؟
يعتمد على خوارزميات معقدة ونماذج التعلم العميق والشبكات العصبية لتحليل البيانات واستخلاص الأنماط، مما يمكنه من التعلم من التجارب السابقة وتحسين الأداء.
• التفاعل مع الشات:
– اضغط Enter للإرسال السريع.
– اضغط Shift+Enter لإضافة سطر جديد.
– جميع المحادثات تتم معالجتها فورياً ولا يتم تخزينها، مع احترام كامل للخصوصية.